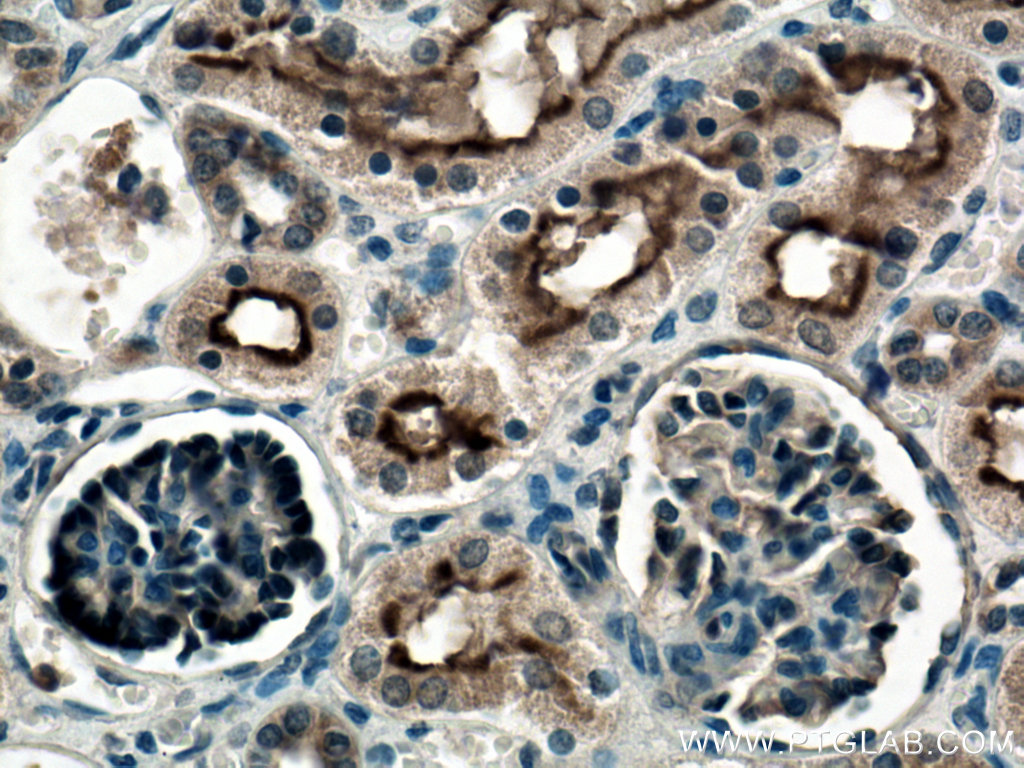

验证数据展示
经过测试的应用
| Positive WB detected in | mouse kidney tissue, human kidney tissue, rat kidney tissue |
| Positive IHC detected in | human kidney tissue Note: suggested antigen retrieval with TE buffer pH 9.0; (*) Alternatively, antigen retrieval may be performed with citrate buffer pH 6.0 |
| Positive IF-P detected in | mouse kidney tissue |
| Positive IF/ICC detected in | Ramos cells |
推荐稀释比
| 应用 | 推荐稀释比 |
|---|---|
| Western Blot (WB) | WB : 1:500-1:2000 |
| Immunohistochemistry (IHC) | IHC : 1:50-1:500 |
| Immunofluorescence (IF)-P | IF-P : 1:50-1:500 |
| Immunofluorescence (IF)/ICC | IF/ICC : 1:400-1:1600 |
| It is recommended that this reagent should be titrated in each testing system to obtain optimal results. | |
| Sample-dependent, Check data in validation data gallery. | |
发表文章中的应用
| WB | See 2 publications below |
| IF | See 2 publications below |
产品信息
23898-1-AP targets Neprilysin/CD10 in WB, IHC, IF/ICC, IF-P, ELISA applications and shows reactivity with human, mouse, rat samples.
| 经测试应用 | WB, IHC, IF/ICC, IF-P, ELISA Application Description |
| 文献引用应用 | WB, IF |
| 经测试反应性 | human, mouse, rat |
| 文献引用反应性 | human, mouse |
| 免疫原 |
CatNo: Ag20963 Product name: Recombinant human MME,CD10 protein Source: e coli.-derived, PET30a Tag: 6*His Domain: 427-527 aa of BC101658 Sequence: YVEAAFAGESKHVVEDLIAQIREVFIQTLDDLTWMDAETKKRAEEKALAIKERIGYPDDIVSNDNKLNNEYLELNYKEDEYFENIIQNLKFSQSKQLKKLR 种属同源性预测 |
| 宿主/亚型 | Rabbit / IgG |
| 抗体类别 | Polyclonal |
| 产品类型 | Antibody |
| 全称 | membrane metallo-endopeptidase |
| 别名 | MME, MME,CD10, EPN, Enkephalinase, EC:3.4.24.11 |
| 计算分子量 | 750 aa, 86 kDa |
| 观测分子量 | 90-110 kDa |
| GenBank蛋白编号 | BC101658 |
| 基因名称 | CD10 |
| Gene ID (NCBI) | 4311 |
| RRID | AB_2879354 |
| 偶联类型 | Unconjugated |
| 形式 | Liquid |
| 纯化方式 | Antigen affinity purification |
| UNIPROT ID | P08473 |
| 储存缓冲液 | PBS with 0.02% sodium azide and 50% glycerol, pH 7.3. |
| 储存条件 | Store at -20°C. Stable for one year after shipment. Aliquoting is unnecessary for -20oC storage. |
背景介绍
CD10, also known as neprilysin, membrane metallo-endopeptidase (MME), neutral endopeptidase (NEP), or common acute lymphoblastic leukemia antigen (CALLA), is a 100-kDa type II transmembrane glycoprotein belonging to peptidase M13 family (PMID: 7760013; 8102558). Among hematopoietic cells, CD10 is expressed on granulocytes, B cell precursors, mature germinal center B cells, a subset of immature thymocytes (PMID: 13679451). CD10 is also expressed on a variety of nonhematopoietic cell types, including bronchial epithelial cells, cultured fibroblasts, bone marrow stromal cells, renal proximal tubular epithelial cells, breast myoepithelium, biliary canaliculi (PMID: 8102558). CD10 is a cell surface peptidase that cleaves peptide bonds on the amino side of hydrophobic amino acids and inactivates a variety of physiologically active peptides. Loss or decreases in CD10 expression have been reported in a variety of malignancies (PMID: 16054017).
实验方案
| Product Specific Protocols | |
|---|---|
| IF protocol for Neprilysin/CD10 antibody 23898-1-AP | Download protocol |
| IHC protocol for Neprilysin/CD10 antibody 23898-1-AP | Download protocol |
| WB protocol for Neprilysin/CD10 antibody 23898-1-AP | Download protocol |
| Standard Protocols | |
|---|---|
| Click here to view our Standard Protocols |
发表文章
| Species | Application | Title |
|---|---|---|
Biochem Cell Biol IL-6 induced enhanced clearance of proANP and ANP by insulin-degrading enzyme in T1DM mouse. | ||
J Biochem Mol Toxicol miRNA-211-5p inhibition enhances the protective effect of hucMSC-derived exosome in Aβ1-40 -induced SH-SY5Y cells by increasing NEP expression | ||
J Transl Med Lysine acetyltransferase 14 mediates TGF-β-induced fibrosis in ovarian endometrioma via co-operation with serum response factor | ||
Nat Commun A gatekeeper sympathetic control of lacrimal tear secretion and dry eye onset through the NA-Adra1a-Ucp2 pathway |